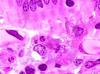
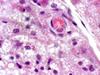
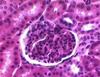
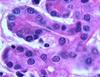

Images Flashcards
(78 cards)
what is pictured

hyaline cartilage
what is pictured

longitudinal section of skeletal muscle
what is pictured

autonomic ganglia
what is pictured
a macrophage in the center of the image
What is pictured lining the lumen

pseudostratified columnar
What is pictured

a compound tubular acinar gland
what is pictured

a Volkmann canal in compact bone extending from a Haversian canal
what is pictured

an osteoclast, osteoblasts, osteoid, endochondral bone formation
what is pictured
brown adipose (and a blood vessel)
what is pictured

decalcified compact bone (below) and medullary area (above)
What is pictured (the extension into the white underlying tissue)

a simple gland (sweat gland)
What is pictured

mucous glands on the left and serous glands on the right
what is pictured

section of elastic artery
What is pictured

compound serous acini glands
what is pictured

mast cell, fibroblasts, and loose CT
what is pictured

autonomic ganglia
what is pictured

elastic ligament
What is pictured? What are the striations in the cell?

Simple columnar epithelia. Basal infoldings.
what is pictured

hyaline cartilage
what is pictured

osteoblasts, osteoid, osteocytes, and RBCs
what is pictured

a mast cell in loose connective tissue
what is pictured

pseudostratified columnar epithelium and goblet cells
What is pictured and what can be identified

Intestinal brush boarder composed of microvilli, simple columnar epithelia and goblet cells. Terminal bar at base of microvilli
what is pictured

a muscular artery with elastin stain